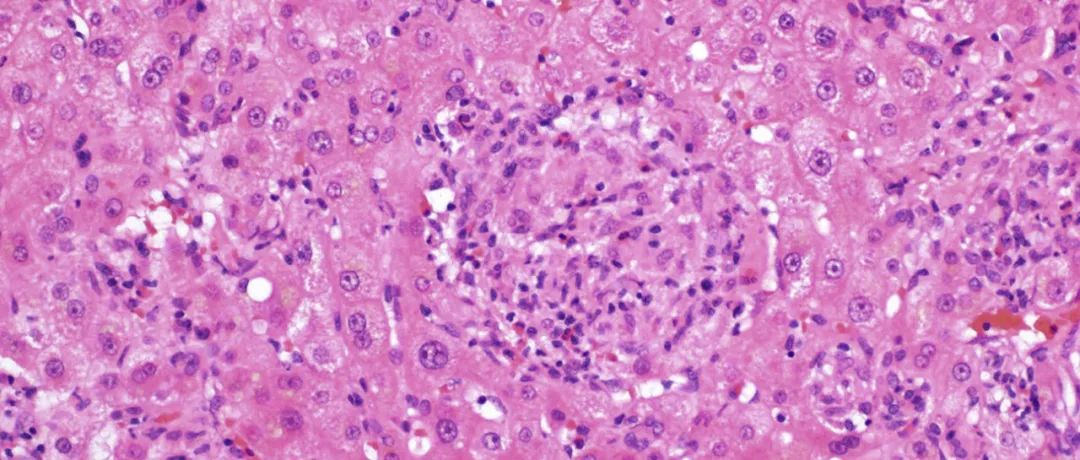

当肝脏遇到肉芽肿(二)
关注华夏病理丨获取更多病理资讯细菌感染所致肝脏肉芽肿 多种分枝杆菌感染可导致肉芽肿,如结核分枝杆菌、麻风分枝杆菌、鸟-胞内分枝杆菌复合体。结核分枝杆菌是结核病的病因,肝脏结核最常见与肺结核有关,累及肝脏的结核大部分是肺部粟粒性结核血道播散所致,且肝脏也是肺外局灶结核的常见部位。相关症状和体征可有发热、腹痛、肝肿大、血清肝脏相关的酶水平升高(最常见为碱性磷酸酶和γ-谷酰基转移酶)。组织学上,结核分枝杆菌所致肉芽肿为上皮样,常伴干酪样坏死及巨细胞。需抗酸染色来观察病原菌,但其敏感性较低;微生物培养及PCR为有用辅助手段。...
皮肤非感染性肉芽肿-临床及病理简明要点(一)
关注华夏病理丨获取更多病理资讯皮肤肉芽肿性病变病种繁多,具体可分为感染性及非感染性两大类。对于皮肤感染性肉芽肿来说,查见病原体对于确诊有极大帮助;但未查见明显病原体情况下,非感染性肉芽肿的诊断及鉴别诊断却较为困难。皮肤非感染性肉芽肿的诊断,一般需密切结合临床及多项辅助检查结果,才能得出最终结论。2015年,加拿大医学专家Kamil等人在《J Clin Pathol》杂志发表综述,简明扼要的介绍了皮肤非感染性肉芽肿性病变中部分重要病种的特征。为帮助大家更好的了解相关问题并指导临床实践,我们将该文要点编译介绍如下。...
新技术,新问题-黏膜下注射剂所致肉芽肿
对于胃肠道早期肿瘤来说,内镜下黏膜切除术(endoscopic mucosal resection,EMR)和内镜黏膜下剥离术(endoscopic submucosal dissection,ESD)是比较先进的治疗技术。通过这类技术,可以切除局限于黏膜或黏膜下的肿瘤,使得患者免于更加激进的手术治疗。EMR和ESD手术中,会在病变下方注射溶液、使得病灶抬举起来,且形成一个液体填塞区使得黏膜下层和固有肌层分离开来,从而利于手术操作。以往使用的液体是混有染液的盐水。尽管这类液体无毒、价廉,但却可以被周围组织快速吸收,导致填塞作用丧失,较长时间、较复杂操作中需要重复注射。此外还有很多其他制剂用于这一目的,如透明质酸、琥珀酰明胶、羟乙基淀粉、葡萄糖水。尽管这些物质相比盐水染液来说有了一定改进,但目前都没有被广泛用于相关操作的金标准。...